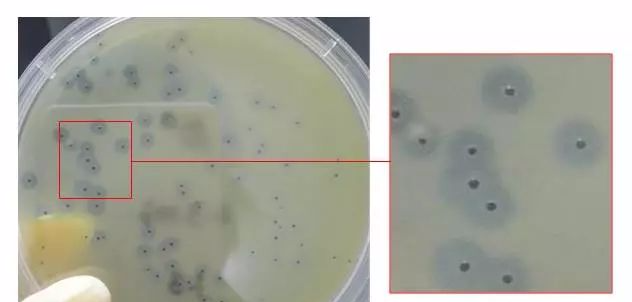
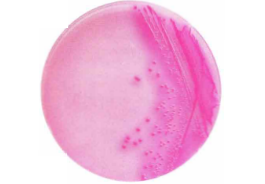

01大腸菌群
大腸菌群:是指一群能發酵乳糖、產酸、產氣、需氧和兼性厭氧的革蘭氏無芽孢桿菌 。該菌主要來源于人畜糞便,大腸菌群是評價食品衛生質量的重要指標之一。
目前,食品中大腸菌群檢測方法國內主要采用GB 4789.3-2025和GB/T 4789.3-2003標準、進出口企業采用的ISO方法或者客戶提供的檢測方法等。
目前國內的GB/T 4789.3-2003標準:采用三步法,即:乳糖發酵試驗、分離培養和證實試驗;而GB 4789.3-2025標準,采用兩步法,即:發酵推測實驗、證實實驗。
檢測該菌的方法主要有MPN法,平板計數法。
MPN法中主要用到的是LST、BGLB、EC肉湯等。
平板計數法主要是VRBA、去氧膽酸鹽等。


1、 LST、BGLB、EC等在滅菌時小倒管中氣泡排不盡;
2、滅菌后培養基顏色異常;
3、滅菌后培養基出現沉淀;
4、培養后氣泡不易觀察;
5、VRBA、去氧膽酸鹽平板上菌落特征不易辨認;
6、平板法培養基不凝固等。
1、在分裝LST、BGLB、EC時,小倒管中有水柱;此外,高壓滅菌時,需急排氣,滅菌后迅速冷卻。
2、在制備過程中過度加熱;水質不佳(GB/T 27405-2008標準中5.4.2.5中強調實驗室培養基、試劑及稀釋劑配制用水應經蒸餾、去離子或反滲透處理,電阻率在25℃時應≥300 000 Ω.m,建議每周檢測一次);或者脫水培養基質量差。
3、在發酵試驗工作中,經常可以看到在發酵倒管內極微少的氣泡(有時比小米粒還小),有時可以遇到在初發酵時產酸或沿管壁有緩緩上浮的小氣泡。實驗表明,大腸菌群的產氣量,多者可以使發酵倒管全部充滿氣體,少者可以產生比小米粒還小的氣泡。如果對產酸但未產氣的乳糖發酵如有疑問時,觀察氣泡時,可以用手輕輕打動試管,如有氣泡沿管壁上浮,即應考慮可能有氣體產生,然后作進一步試驗。
4、熟悉大腸菌群在上述平板上的特征,必要可做一些陽性的對照。有些食物殘渣會影響觀察結果,這樣需要我們在培養前仔細觀察平板的狀態,大的食物殘渣可以做一些標記。
5、一般是在制備過程中稱量不正確、或者培養基制備后未充分混勻。
金黃色葡萄球菌:是人類化膿感染中最常見的病原菌,可引起局部化膿感染,也可引起肺炎、敗血癥等,其毒性的強弱取決于產生的毒素和侵襲性酶,例溶血素酶、殺白細胞素、血漿凝固酶、脫氧核糖核酸酶。
我國國家衛生和計劃生育委員會于 2021年9月發布了《食品安全國家標準 食品中致病菌限量》(GB 29921-2021),在國標中制定了金黃色葡萄球菌的限量標準,規定肉制品、糧食制品、即食豆制品、即食果蔬、即食調味品等7大類食品中,同批次采集 5 份樣品,每份樣品中的金黃色葡萄球菌濃度均不得超出 1000 CFU/g,僅允許其中1份樣品在 100~1000 CFU/g之間。
新版標準中還增加了乳制品中金黃色葡萄球菌的限量要求。
目前,國內檢測食品中金黃色葡萄球菌依據國家標準《食品微生物學檢驗 金黃色葡萄球菌檢驗》(GB4789.10-2016)檢測該菌的方法主要有MPN法,平板計數法;主要用到的是7.5%氯化鈉肉湯、Baird-Parker平板,血平板等。
B-P瓊脂上金黃色葡萄球菌有黑色的菌落中心,周圍有半透明的卵磷脂沉淀環。金黃色葡萄球菌在B-P上的菌落特征如下圖:

1、7.5%氯化鈉肉湯中呈混濁生長,怎么判斷;
2、平板的狀態:透明、有絮狀物。
3、凝固酶實驗的觀察。
1、由于食品顆粒的影響,這步不容易觀察,最好是進行下一步驗證。
2、不同的廠家的培養基平板制好后的狀態有所不同,主要取決于亞碲酸鉀卵黃增菌液的不同。根據各廠家的培養基說明制定相應的實驗室SOP.
3、在添加亞碲酸鉀卵黃增菌液時,溫度的掌握,不宜太高,過高易使卵黃變性,也不應太低,太低瓊脂易凝固。
4、將金黃色葡萄球菌接種到兔血漿上后,每半小時觀察一次,觀察凝固時,將血漿輕輕傾斜或慢慢倒置,如有流動,既證明沒有凝固。不同廠家的凍兔血漿,可能會有差異,仔細閱讀作業指導書。